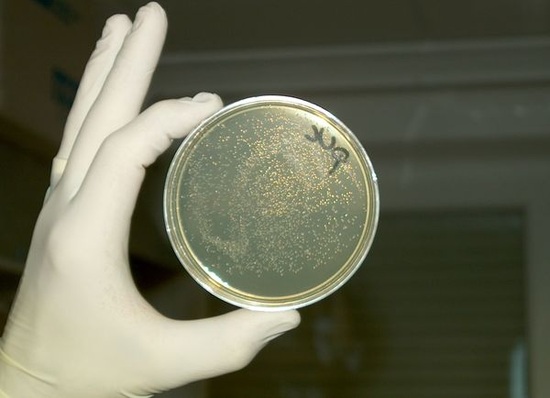

Seit vielen Jahren arbeiten Fachleute unter der Leitung des VDI an der Eliminierung von Hygienerisiken in der Raumluftqualität durch Richtlinien für Raumlufttechnik. Die luftseitigen Problemfälle in den USA, Frankreich, Spanien und Großbritannien haben verdeutlicht, wie eminent wichtig eine eindeutige Hygienerichtlinie erforderlich ist. Aber immer noch scheuen sich einige Kreise vor der konsequenten Umsetzung entsprechender Maßnahmen. Dabei haben die Ergebnisse einer Studie von nahezu 250 untersuchten RLT-Anlagen vor einigen Jahren die Notwendigkeit der VDI-Richtlinie 6022 „Hygiene-Anforderungen an Raumlufttechnische Anlagen und Geräte“ eindeutig belegt. Die auf freiwilliger Basis durchgeführte Untersuchung betraf zum Großteil Anlagen der Industrie und öffentlicher Einrichtungen.
Trotzdem weisen RLT-Anlagen immer wieder nicht tolerierbare Verkeimungen, eine unzulässige Staubbelastung durch zu niedrige Filterstufen und durchgeschlagene Filter auf. Häufig findet man Kondenswasserlachen vor, was wiederum Korrosion von Bauteilen und zusätzliche Hygienerisiken zur Folge hat. Derartige Feststellungen haben zwar keine Allgemeingültigkeit und lassen somit keine direkten Interpretationen – auch wegen des unterschiedlichen Alters von RLT-Anlagen – zu. Konkret lässt aber schon das unbestrittene Einordnen dieser Defizite als Mängel den Schluss zu, dass die Unternehmen in Planung, Ausführung, Betrieb und Wartung die Notwendigkeit der Hygienerichtlinien nunmehr erkannt haben und sie in der Praxis auch umsetzen.
Auch wenn für Deutschland (noch) kein Fall einer luftseitig ausgelösten Legionellen-Infektion belegt ist, gibt es dennoch viel zu tun im Bereich des Lebensmittels Luft. Denn nach nur wenigen Jahren wurde auch die VDI 6022 auf den Prüfstand gestellt und überarbeitet. Eine der wesentlichen Änderungen ist, dass die Verantwortlichkeiten von Planern, Komponentenherstellern, Anlagenbauern und Betreibern neu definiert wurden und dabei den Planern ein hohes Maß an Verantwortung übertragen wurde.
Welche Bedeutung der Hygiene in der Technischen Gebäudeausrüstung mittlerweile beigemessen wird, unterstreicht auch die nach dem ersten Erscheinen der VDI 6022 begonnene Harmonisierung des gesamten VDI-Richtlinienwerks auf diese „Hygiene-Richtlinie“. Einige Beispiel sind VDI 3801 „Betreiben von RLT-Anlagen“, VDI 3803 „Bauliche und technische Anforderungen an RLT-Anlagen“ sowie VDI 2079 „Abnahmeprüfung von RLT-Anlagen“, deren Anforderungen zur Hygiene von RLT-Anlagen in VDI 6022 konkretisiert werden. Eine ähnliche Entwicklung gibt es im Sanitärbereich des VDI-Regelwerks. Mit VDI 6023 sollen Hygienerisiken im Trinkwasserbereich minimiert werden. Aufgeschreckt durch das Bekantwerden von Legionellen im Trinkwasser zweier renommierter Berliner Luxushotels vor einiger Zeit kommt seitdem der Hygieneinspektion auch im Trinkwasserbereich die notwendige Bedeutung zu.
Ziele der VDI 6022
Ziele der VDI 6022 sind es, von einer ausgereiften Planung über eine hygienebewusste Ausführung, einen hygienegerechten Betrieb und eine ebensolche Instandhaltung und Wartung sicherzustellen. Regelmäßige Hygienekontrollen ergänzen die Anforderungen an Bauherren, Architekten, beratende Ingenieure, Anlagenbauer, Geräte- und Komponentenhersteller, Genehmigungsbehörden, Sachverständige, Betreiber und Wartungsunternehmen. Basis ist die Ausbildung aller betroffenen Personenkreise.
Die geforderte Hygieneschulung des Personals wird mit der Teilnahme an einem speziellen Seminar erfüllt, das die notwendigen Kenntnisse über Hygiene bei RLT-Anlagen vermittelt. Zielgruppe sind Facharbeiter, Techniker und Ingenieure, die sich mit Planung, Montage, Wartung, Reparatur und anspruchsvollen Hygienetätigkeiten von RLT-Anlagen beschäftigen und nach DIN/VDI über die Hygiene solcher Anlagen unterrichtet werden müssen. Am Ende des Seminars steht eine Prüfung mit Zertifikatserteilung.
Nutzen der VDI 6022
Jeder Beteiligte im Lebenszyklus einer RLT-Anlage hat ein Interesse an der Hygiene-Sicherheit. So werden beim Betreiber Kosten für verminderte Produktivität, Arbeitsausfall bzw. verzögerte Genesung durch hygienische Mängel verhindert und gesundheitliche Beschwerden der Personen in den belüfteten Räumen vermieden.
RLT-Geräte- bzw. -Komponentenhersteller, die die Anforderungen der VDI 6022 erfüllen, können sich dies durch qualifizierte Hygieneexperten in Form einer Baumusterprüfung bestätigen lassen. Dies führt zu einem qualifizierten Hygienestandard, erhöhter Planungssicherheit und damit zum Ausschluss von Regressansprüchen als Folge von Hygienemängeln.
Bei entsprechender Schulung aller beteiligten Personen von der Planung bis zur Instandhaltung ist die Einhaltung des Hygienestandards weniger kostenaufwendig als oft behauptet. Denn treten gesundheitliche Beschwerden infolge hygienischer Mängel auf, haben die Betroffenen oder die Kontrollorgane erstmals die Möglichkeit, die Anlagen zu überprüfen und die Mängel beseitigen zu lassen. Günstiger als eine von Anfang an hygienegerechte Lösung kann ein solcher Vorgang niemals sein.
Was auf den ersten Blick Ängste bei den Betroffenen weckt, ist bei genauerem Hinsehen ein bedeutsamer Schritt, der die RLT-Anlage und deren Komponenten ins rechte Licht rückt. Durch die Hygieneinspektion erhält ein Betreiber von RLT-Anlagen einen objektiven Eindruck vom Zustand seiner Anlagen. Damit können die Wartung besser gesteuert, Instandsetzungen rechtzeitig erkannt und kostenintensive Sanierungen langfristig vermieden werden. Die Beachtung des Richtlinien-Blatt ist also nicht nur aus hygienischer Sicht eine notwendige Maßnahme, sondern auch aus wirtschaftlichen Gründen.
Nicht zuletzt profitiert die gesamte Lüftungstechnik-Branche von dem höheren Hygienestandard durch Hygieneanforderungen. VDI 6022 vermindert nicht nur die mit Lüftungsanlagen in Verbindung stehenden Hygiene-Probleme, sondern bewirkt auch, dass sie ihren Ruf als „Keimschleudern“ verlieren und dass das zurückgewonnene Vertrauen die Akzeptanz von Lüftungstechnik in allen Lebensbereichen erhöht.
Keine unverbindliche Richtlinie
VDI 6022 ist in viele Vorschriften direkt oder indirekt eingebunden, weil diese für den jeweiligen Rechtsbereich den Stand der Technik fordern, und sie wird im Streitfall als Basis herangezogen. Beispielsweise fordert das deutsche Arbeitsschutzgesetz, dass der Arbeitgeber bei Maßnahmen des Arbeitsschutzes den Stand der Technik, Arbeitsmedizin und Hygiene sowie sonstige gesicherte arbeitswissenschaftliche Erkenntnisse zu berücksichtigen hat. Weitere gesetzliche Vorschriften, aus denen sich eine Verbindlichkeit der VDI 6022 ableitet, sind unter anderem die Arbeitsstättenverordnung, Arbeitsstättenrichtlinie und die Vergabe- und Vertragsordnung für Bauleistungen (VOB).
Zudem haben eine Reihe der für Arbeitsschutz, Gesundheitsschutz und technische Sicherheit verantwortlichen Landes-Aufsichtsbehörden die Überprüfung der Einhaltung der VDI 6022 in ihr Kontrollprogramm (Hygienekontrollen) übernommen bzw. eigene Programme zur Überprüfung der Einhaltung der VDI 6022 erstellt.
Bei Bauverträgen gilt der „Stand der Technik“ als stillschweigend vereinbart, auch wenn er nicht explizit erwähnt ist. Dies gilt verschärft für VOB-Verträge, da VOB/C DIN 18379 die VDI 6022 ausdrücklich als „für die Ausführung geltend“ nennt. Daneben haben Architekt und Fachplaner die Einhaltung der anerkannten Regeln der Technik zum Zeitpunkt der Abnahme zu realisieren. Die Einhaltung der anerkannten Regeln der Technik wird allerdings nicht automatisch durch die Beachtung gültiger Normen gewährleistet. Durch eine länger zurückliegende Überarbeitung können sie hinter den anerkannten Regeln der Technik zurückbleiben.
Architekten, Planer, Anlagenbauer, Komponentenhersteller, Betreiber und Wartungsunternehmen haben also stets den Stand der Technik zu beachten, andernfalls liegt ohne ausdrücklich abweichende vertragliche Vereinbarungen sowohl nach VOB als auch nach dem BGB ein Mangel vor. Dies gilt auch, wenn Normen und Richtlinien bzw. Raumluftqualitäts-Blätter nicht explizit in der Ausschreibung oder im Leistungsverzeichnis genannt sind. Selbst wenn die Ausschreibung den Richtlinien widerspricht, muss im Rahmen der Vertragsnebenpflichten (Aufklärungs-, Prüfungs- und Beratungspflichten) auf diesen Widerspruch (schriftlich) hingewiesen werden. Auch wenn die Anforderungen nicht ohne Kosten zu erfüllen sind, ist der Stand der Technik anzuwenden.
Fazit
„Muss das wirklich sein?“, heißt es in der Überschrift. Bezogen auf die Inhalte der VDI-Richtlinie 6022 kann es dazu nur ein klares Ja geben. Bezogen auf die Bilder, kann es dazu nur ein klares Nein geben. Leider kann man sie auch heute noch bei viel zu vielen Anlagen photographieren.
Detlef Hagenbruch
Dipl.-Ing., VDI, ASHRAE, TGA-Netzwerk, Köln, hat in zahlreichen Ländern im südostasiatischen Raum, den USA und in den Vereinigten Emiraten durch seine Arbeit, Vorträge und Fachpublikationen und seine Mitarbeit zu einer wesentlichen Verbesserung der dortigen hygienischen Grundanforderungen von RLT-Anlagen beigetragen. E-Mail: detlef.hagenbruch@koeln.de